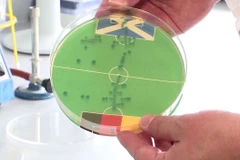
Kết quả dự đoán bằng vi khuẩn E.coli cho thấy đội tuyển Đức giành thắng lợi trong trận mở màn EURO 2024 với Scotland. (Nguồn: Mạng xã hội X)

EURO 2024: Dùng vi khuẩn E.coli để dự đoán kết quả trận đấu
Theo nhà vi trùng học Markus Egert, càng có nhiều khuẩn lạc phát triển trong vòng cấm của một đội, càng có nhiều bàn thắng được ghi vào lưới, từ đó sử dụng sự phân bố của vi khuẩn để dự đoán kết quả.








![[News Game] Dự đoán kết quả trận mở màn EURO giữa Pháp và Romania](https://media.vietnamplus.vn/images/47644295deb266624e118afe1529aeb8e4220b3edae4710d222fe13eea2fc3807e0007ec1edab56497d138fdaa06155e28380d40230fb06f0fdc86dd75a55927/phap_Romania.jpg.webp)